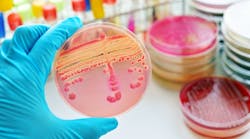
Colonies of bacteria in culture medium plate Colonies of bacteria in culture medium plate

February 2026
OSHA Rule Changes 2026: What it Means for Contractors; $46M Wastewater Upgrade Advances; Construction Input Prices Rise in Nov.; The Role of AI in Contracting; Digital Progress - Digital Risk; KBIS 2026 Spotlights Wellness, Personalization and Innovation; and much more.